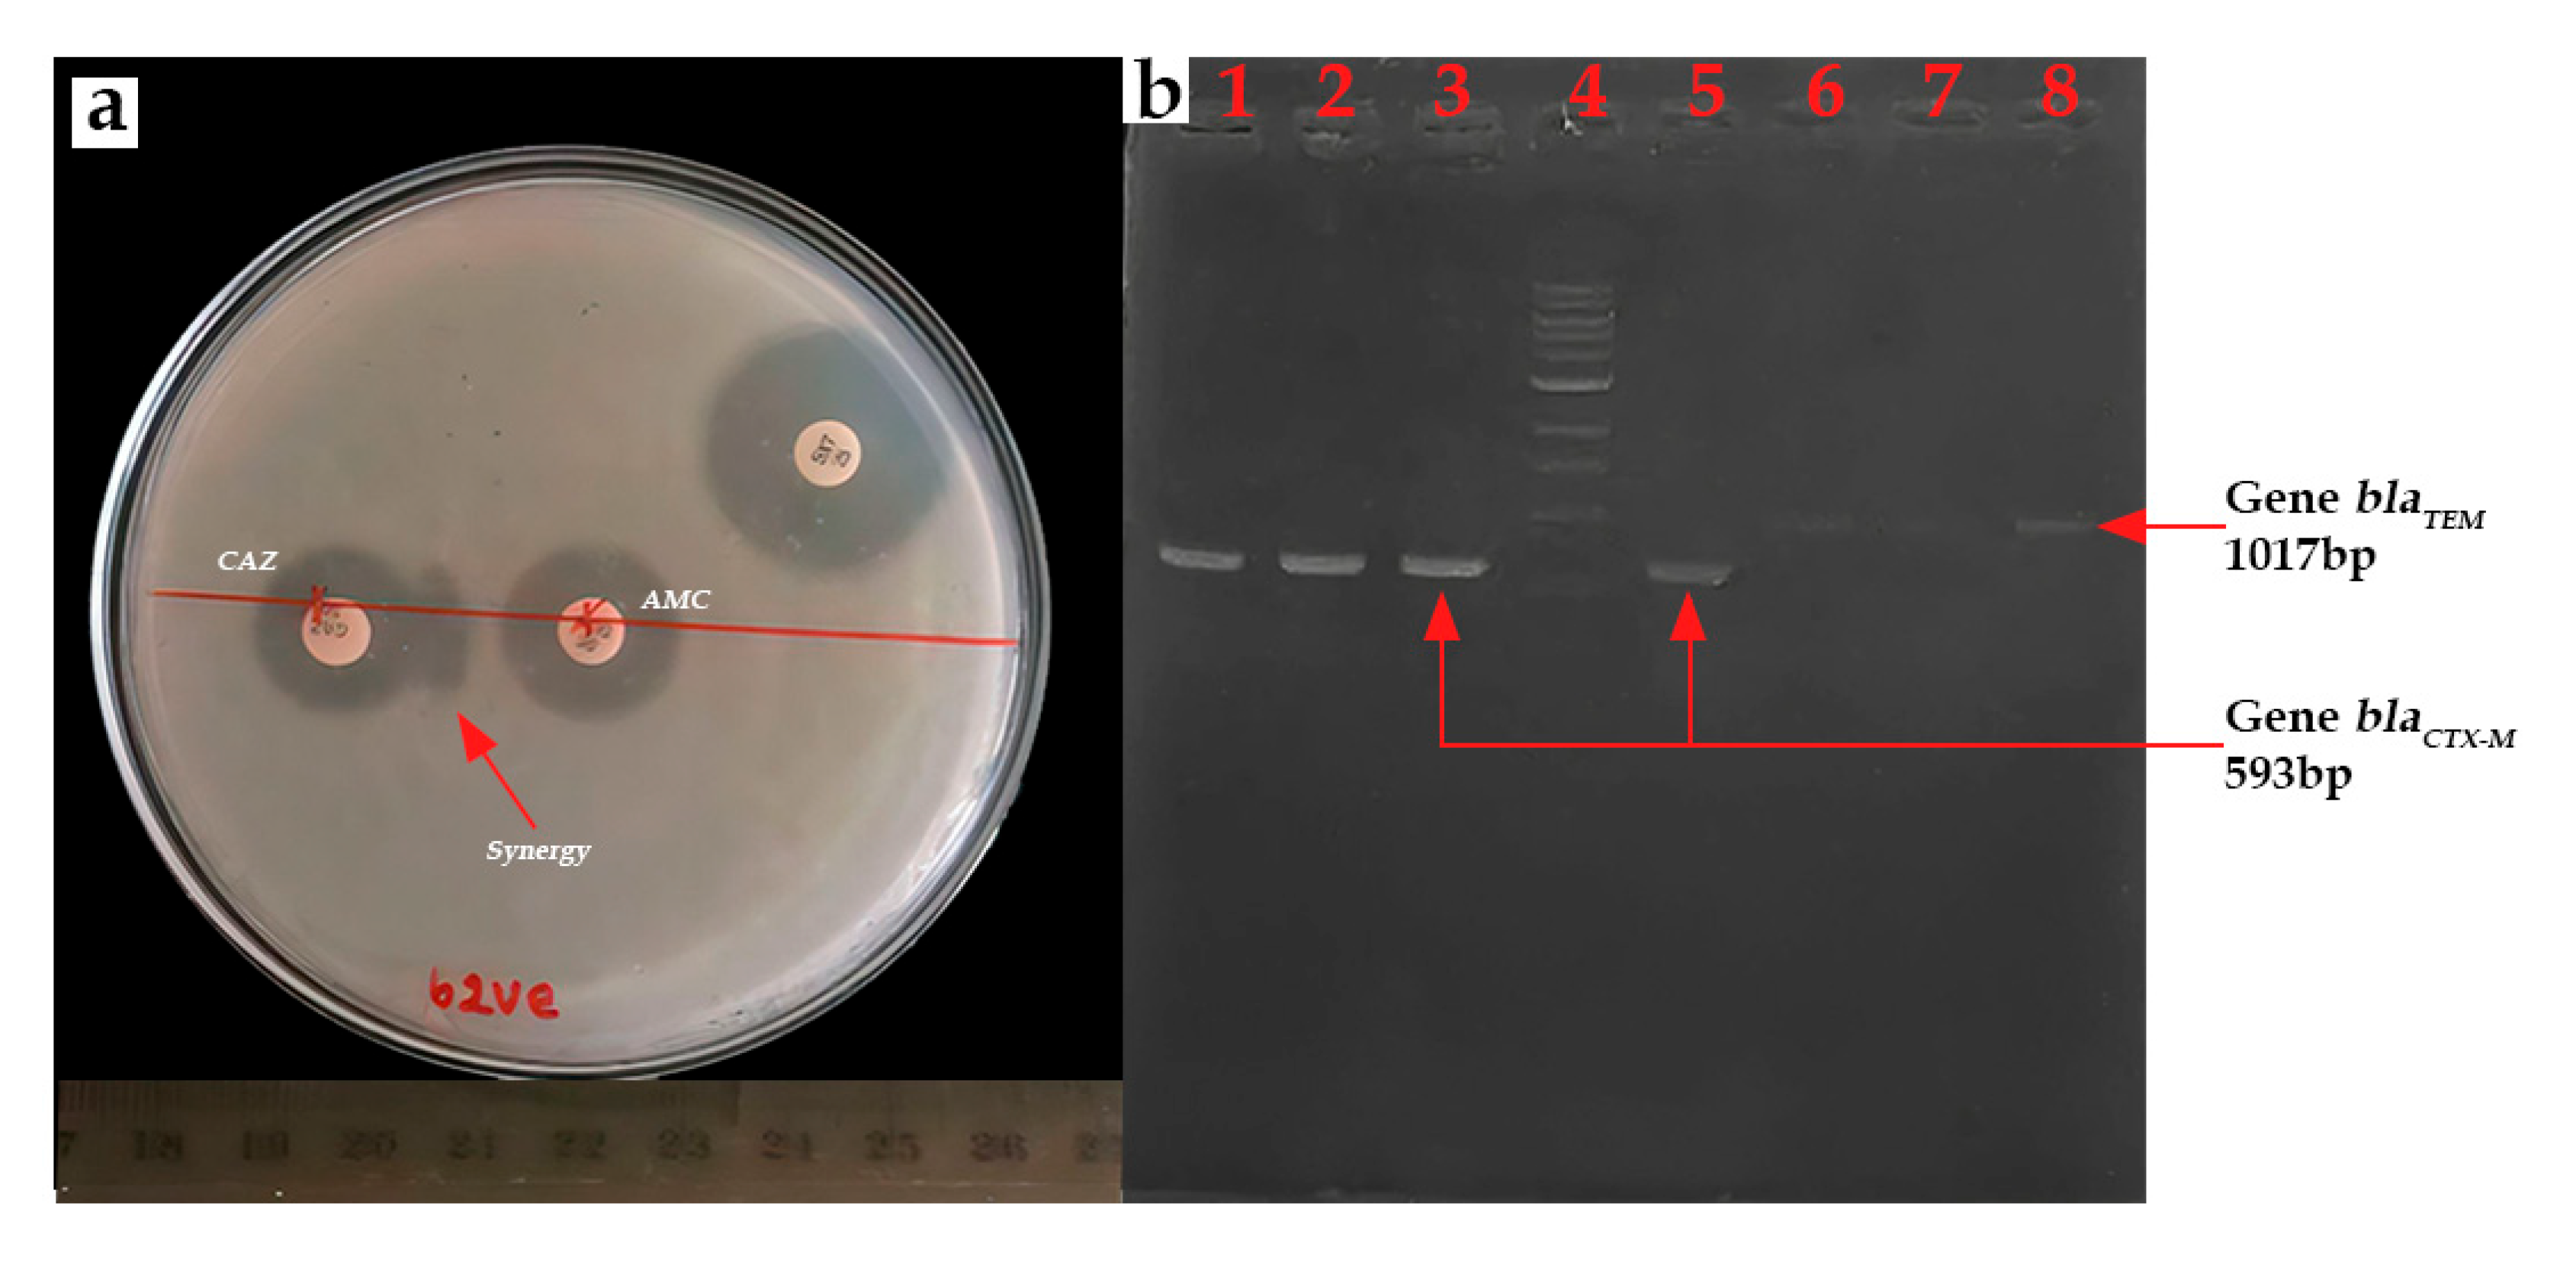
Microorganisms 13 01997 g008 Microorganisms 13 01997 g008

Abstract
The emergence and dissemination of extended-spectrum beta-lactamase (ESBL)-producing bacteria pose a major public health threat, necessitating a One Health approach to addressing this threat. Thus, the diversity, ESBL production, and potential public health implications of Gram-negative bacteria recovered from man-made lakes and surrounding lettuce in Yamoussoukro, Côte d’Ivoire were assessed in this study. Also, the lakes’ physicochemical parameters were assessed and correlated with bacteria community using Pearson correlation. A total of 68 Gram-negative bacterial isolates were recovered from the samples and identified via 16S rDNA gene sequencing. Phylogenetic analysis suggested multiple genus-/species-level variations within the isolates. Escherichia coli was the most prevalent in lake water (39.5%), while Acinetobacter was the dominant genus in lettuce (30%). E. coli isolates showed high resistance to ampicillin (90.9%), cefepime (72.7%), cefotaxime (68.2%), and aztreonam (63.6%). Moreover, ESBL production was confirmed in E. coli isolates (22.05%), predominantly mediated by the blaCTX-M gene. Multidrug-resistant phenotypes were widespread, yielding similar multiple antibiotic resistance index (MARI) values in water (0.27–0.63) and lettuce (0.27–0.81). These data indicate high environmental contamination, which unfortunately is not being taken into account by lettuce producers according to an interview. Statistical analyses showed a significant relationship between bacterial diversity and lakes’ physicochemical parameters, including dissolved oxygen, pH, and turbidity. The basic education level of farmers, the prevalence of ESBL-producing E. coli, and the high prevalence of MDR Gram-negative bacteria in both environmental and crop sources in Yamoussoukro underscore the need for both integrated surveillance and management strategies to mitigate potential microbial public health risks within a One Health framework.
1. Introduction
Gram-negative bacteria (GNB) constitute a vast and heterogeneous group of bacteria, distinguished by their complex cell wall structure, which includes an outer membrane that enhances their ability to survive in harsh environments and contributes to their resistance to various antibacterial agents [1,2]. Two major groups, Enterobacteriaceae (e.g., Escherichia coli, Enterobacter spp., Proteus mirabilis, and Citrobacter spp.) and non-fermenters, such as Pseudomonas aeruginosa and Acinetobacter baumanii, have been identified as environmental organisms, as well as opportunistic pathogens, with the potential to cause infections in humans and animals [3].
Currently, one of the most significant global health challenges is the emergence of multidrug-resistant (MDR) Gram-negative infections [3]. The intrinsic resistance mechanisms of these bacteria, in conjunction with their notable capacity for the acquisition and horizontal transfer of resistance genes via plasmids, transposons, and integrons, contribute to their emergence and dissemination as MDR strains [4]. The World Health Organization (WHO) has published a list of “priority pathogens,” which are increasingly difficult to treat [5]. Many of these pathogens are found to harbor an extended-spectrum beta-lactamase (ESBL) resistance mechanism [5]. Extended-spectrum beta-lactamases, primarily CTX-M, TEM, and SHV, are enzymes that facilitate the hydrolysis of extended-spectrum cephalosporins [6]. Of this family of enzymes, the most prevalent are CTX-M and its variations. As evidenced in more recent studies conducted in South Asia, 33% of E. coli isolates produce ESBL, with the CTX-M gene implicated in 58% of cases [7]. In Ethiopia, 18% of Enterobacteriaceae isolates were identified as ESBL producers [8]. Initially, ESBL outbreaks were primarily associated with hospitals [9]. However, they have since been identified in a range of settings, including water sources.
The role of water as a conduit for the dissemination of MDR bacterial strains has gained significant recognition in recent years [10,11]. The release of antibiotics into wastewater increases selective pressure on bacteria, thereby facilitating the proliferation of antibiotic resistance [12]. Furthermore, wastewater treatment processes are not entirely effective in eliminating microbial contaminants [13]. Consequently, wastewater is frequently discharged into receiving water sources, which allows resistant Gram-negative bacteria and genes encoding antibiotic resistance to reach agricultural soils and waterbodies [14]. For example, the prevalence of ESBL-Enterobacteriaceae in wastewater was estimated to be 24.81% [13]. In regions where untreated water from lakes or rivers is used for irrigation purposes, the transfer of resistant bacteria to vegetables can occur, thereby creating another pathway for human exposure to MDR bacteria [15,16].
Lettuce, a common ready-to-eat vegetable, plays a critical role in transmitting bacteria from the environment to humans, especially when grown in fields irrigated with contaminated water. More importantly, the presence of ESBL-producing bacteria on fresh produce like lettuce is especially concerning due to the potential for these pathogens to be ingested directly and for resistance genes to spread to the human microbiota [17,18]. Studies have shown that ESBL-E. coli can survive on lettuce for up to a week after contamination, highlighting the importance of food safety measures to prevent its spread [19].
Man-made lakes in Yamoussoukro, central Côte d’Ivoire, constitute a significant source of irrigation water for nearby vegetable fields, including lettuce [20]. Preliminary studies have revealed poor water quality and high levels of E. coli, with resistance to multiple antibiotics, including ampicillin, tetracycline, ciprofloxacin, and sulfamethoxazole [21,22]. In another study, E. coli was found on crops irrigated with the lake water [23]. However, there is a lack of information on the specific resistomes and the overall diversity of Gram-negative bacteria present in the lakes and on the crops. Given the growing concern about the role of contaminated environments in the spread of antibiotic-resistant bacteria, it is essential to monitor the presence and diversity of Gram-negative bacteria in water sources and on edible crops. This study focuses on Gram-negative bacteria isolated from man-made lakes in Yamoussoukro, Côte d’Ivoire, as well as the surrounding lettuce fields, which are regularly irrigated with water from the lakes. The goal was to assess the characteristics of these environmental bacteria by examining their diversity, resistance profiles, and multidrug resistance (MDR) potential, with a specific focus on ESBL production and related potential public health implications.
2. Materials and Methods
2.1. Study Area and Sample Collection
This study has been carried out in Yamoussoukro, in central Côte d’Ivoire (6°40′/7°00′ N and 5°10′/5°20′ W) (Figure 1). This city was created with a system of ten man-made lakes and has been established as the political capital of Côte d’Ivoire since 1983. Connected by gravity, these lakes are an important part of the city’s tourist attractions and cultural heritage. Various human activities are carried out around these lakes, including gardening, livestock farming, restaurant operation, etc. For this study, four lakes within the Yamoussoukro Lake system, which have been previously studied with regard to their microbiological quality [21], were selected. The selected lakes were distributed throughout the system: lakes 1 and 8 are located upstream, at the entrance to the two branches of the system; lake 5 is located in the center of the system; and lake 6 is situated downstream of the system (Figure 1). Sampling was conducted over two dry periods: from November 2021 to January 2022 and from September 2022 to November 2022. For each lake, 1000 mL of water was collected in a U-shaped pattern at a depth of 50 cm [24] at three sampling points. A total of 15 water samples were collected for each lake. In consideration of the vegetable crops cultivated in the vicinity of the lakes, lettuce (Lactuca sativa) was identified as a suitable subject for study. A total of eight lettuce plants exhibiting no apparent deterioration or visible cracking were randomly selected within the proximity of each lake and placed in sterile freezer bags. All the collected samples were placed in a cooler at a temperature of 4 °C and transferred to the laboratory as quickly as possible for further analysis.
Figure 1.
Yamoussoukro Lake system and location of study target lakes.
2.2. Survey of Agricultural Producers
The survey was conducted using a structured questionnaire designed on the KoboToolbox platform and administered during face-to-face interviews with consenting farmers (questionnaire available as follows: https://kf.kobotoolbox.org/#/forms/a7NeSfdb4gbSmwexWfmePo, accessed on the 15 February 2024). The objective was to investigate farming practices that may potentially contribute to the microbiological contamination of lettuce crops by Gram-negative MDR bacteria and the extent to which these producers are aware of the microbiological risks. Thus, a total of 65 lettuce growers were surveyed. The questionnaire encompassed several key themes, including sociodemographic data, irrigation water use, agricultural input practices, and post-harvest hygiene and management.
2.3. Physicochemical Analysis of Lake Water
The physicochemical parameters of the lake water were analyzed in order to characterize the environmental conditions that may influence the survival and proliferation of Gram-negative bacteria. The following parameters were measured: pH, temperature, redox potential (mV), turbidity (NTU), conductivity (µS/cm), dissolved oxygen (mgO2/L), total dissolved solids (TDS, mg/L), total hardness (TH, mg/L), nitrate (NO3−, mg/L), nitrite (NO2−, mg/L), phosphate (PO43−, mg/L), ammonium (NH4+, mg/L), bicarbonate (HCO3−, mg/L), calcium (Ca2+, mg/L), and magnesium (Mg2+, mg/L) concentrations. The analyses were conducted in accordance with the standard Afnor methods [25]. The measurements were taken using a multifunctional pH meter (PCE-PHD 1, PCE Instruments, Meschede, Germany) and a spectrophotometer (Jasco V-530 UV/VIS, JASCO Corporation, Japan).
2.4. Isolation of Gram-Negative Bacteria
Prior to isolation, 1 mL of each water sample and 2.5 g of each lettuce sample were enriched in 9 mL of Tryptone Soy Broth (Merck, Darmstadt, Germany) and 22.5 mL of Peptone Water (Oxoid, Basingstoke, UK), respectively, and incubated at 37 °C for four hours. Following the incubation, a three-series ten-fold dilution of each pre-enriched culture was conducted (10−1, 10−2, and 10−3). Subsequently, 100 µL of each prepared dilution, in addition to the pre-enrichment suspensions, were plated in duplicates on distinct media, including Chromocult culture agar (Merck, Darmstadt, Germany), Salmonella-Shigella agar (Oxoid, Basingstoke, UK), and Pseudomonas base agar supplemented with CFC selective supplement (ISO) (Oxoid, Basingstoke, UK). These media are commonly recommended for the isolation of Gram-negative bacilli. To maximize the isolation of resistant strains, all media were also supplemented with 2 mg/mL Ceftazidime. The plates were then incubated at 37 °C for 24 h. When isolates started growing, a sample was restreaked on agar-based medium to isolate single colonies. Thus, all of the isolates described in this study were purified, and a Gram stain was conducted to confirm the Gram type prior to subsequent molecular analyses. In all these analyses, Pseudomonas aeruginosa ATCC 27853 and Escherichia coli ATCC 8739 were used as reference strains.
2.5. Molecular Identification of the Isolates
Genomic DNA of each isolate was extracted from pure colonies following the standard CTAB method [26]. DNA was extracted from colonies that had been grown for 18–24 h, and 5 µL of DNA template was used for PCR assays. Additionally, the universal primers 27F (AGA GTT TGA TCM TGG CTC AG) and 1492R (TAC GGY TAC CTT GTT ACG ACT T) were utilized to amplify the 16S rDNA gene.
The PCR reaction mixture was prepared, resulting in a final volume of 50 µL, comprising 25 µL of OneTaq® Quick-Load® 2X Master Mix with Standard Buffer (New England Biolabs (NEB), Ipswich, MA, USA), 5 µL each of forward and reverse primer (manufactured by Eurofins, Luxembourg, Luxembourg), 5 µL of the DNA template, and sterile distilled water to reach a total volume of 50 µL. The amplifications were conducted using a iCycler™ thermal cycler (Bio-Rad, Hercules, CA, USA), with the following cycling parameters: an initial denaturation at 95 °C for 2 min, followed by 30 cycles of denaturation at 95 °C for 30 s, annealing at 55 °C for 30 s, 72 °C for 1 min 30 s for cycling extension, and a final extension at 72 °C for 2 min. Subsequently, 6 µL of the amplicons were resolved in a 1% agarose gel (Benchmark Scientific, Sayreville, NJ, USA) stained with SafeView (Applied Biological Materials Inc. (ABM), Richmond, BC, Canada)), including a 1 kb DNA ladder (New England Biolabs (NEB), Ipswich, MA, USA, which served as a molecular size standard. The electrophoresis was conducted at 50 volts for 30 min, and the resulting gels were visualized using the UVP Photodoc-it imaging system (Analytik Jena, Jena, Germany). Genomic DNA of P. aeruginosa ATCC 27853 and E. coli ATCC 8739 were utilized as positive controls, while a microtube containing only the DNA-free reaction medium served as the negative control.
2.6. 16S rDNA Sequencing and Phylogenetic Analysis
The PCR product was purified and sequenced using the Sanger method (Inqaba, Pretoria, South Africa). The sequences were then assembled into double-stranded DNA using the BioEdit version 7.25 program and manually edited when necessary. Edited sequences were then compared with those already deposited in GenBank using the BLAST algorithm (NCBI; https://blast.ncbi.nlm.nih.gov, accessed on 25 March 2025) to identify our isolates and find their closely related reference strains. Accession numbers of the isolates are provided in Table S2.
Prior to the phylogenetic reconstruction, a multiple sequence alignment was conducted by aligning the consensus sequences of the 16S rDNA genes with those of the reference type strains collected from GenBank. In brief, the 16S rDNA edited sequences were aligned with MUSCLE as implemented in MEGA software version 11, and the best-fit nucleotide substitution model was selected according to the Bayesian information criterion (BIC) [27]. A subsequent phylogenetic tree was reconstructed using the neighbor-joining (NJ) and maximum likelihood (ML) methods [28,29], with a bootstrap value of 1000 replicates [30]. The resulting tree was visualized with iTool [31].
2.7. Antibiotic Susceptibility Testing
The antibiotic resistance profiles of the identified isolates were analyzed using the standard Kirby–Bauer disc diffusion tests [32], with some modifications. The colonies were selected from 24 h pure cultures, emulsified in sterile 0.9% NaCl solution, and adjusted to match the 0.5 McFarland standard. The mixture was evenly inoculated on Mueller–Hinton agar by flooding the entire surface with the inoculum, and the excess liquid was then carefully removed using a sterile pipette. Antibiotic discs were subsequently added to the agar using sterile forceps. The plates were incubated for 24 h at 37 °C. The inhibition zones were measured in millimeters and classified as susceptible (S), intermediate (I), or resistant (R) according to the standards recommended by the European Committee on Antimicrobial Susceptibility Testing [33]. The breakpoint was displayed in Table S1. Antibiotics included in the analysis were gentamycin (CN-10 µg), ampicillin (AMP-10 µg), amoxicillin–clavulanic acid (AMC-20/10 µg), ticarcillin–clavulanic acid (TIM-75/10 µg), imipenem (IMP-10 µg), cefotaxime (CTX-30 µg), cefepime (FEP-30 µg), ceftazidime (CAZ-30 µg), ciprofloxacin (CIP-5 µg), cefoxitin (FOX-30 µg), chloramphenicol (C-30 µg), and aztreonam (ATM-30 µg) (Oxoid, Basingstoke, UK). Concurrently, the double synergy test was conducted by placing discs of amoxicillin + clavulanic acid or ticarcillin + clavulanic acid 2.5 cm apart [34,35]. Isolate was identified as an ESBL producer when a “champagne cork” synergy was observed. Escherichia coli ATCC 8739 and an in-house ESBL-E. coli strain were utilized as reference strains for the negative and positive controls.
2.8. Evaluation of Multiple Antibiotic Resistance Phenotypes (MARPs) and the Multiple Antibiotic Resistance Index (MARI)
The resistance of isolates against three or more antibiotics was used as a criterion to identify MDR strains [36]. Subsequently, the multiple antibiotic-resistant phenotypes (MARPs) were assessed for each MDR isolate, and its multiple antibiotic resistance index (MARI) was then generated using the following mathematical equation [37]:
where “a” denotes the number of antimicrobial agents to which the isolates exhibit resistance to and “b” indicates the total number of antimicrobial agents against which each isolate was tested. MARI that is equal to or greater than 0.2 shows that antimicrobial agents are intensively used in that area, thus promoting the emergence of antibiotic resistance [37,38].
2.9. Screening for ESBL Resistance Genes
Following the double synergy test, the isolates that exhibited the “champagne cork” synergy were subjected to screening for the presence of three common ESBL antibiotic resistance encoding genes (blaTEM, blaCTX-M, and blaSHV) using the PCR technique. The primer sequences, as well as their amplicon size and cycling conditions, are listed in Table 1. E. coli ATCC 8739 and an in-house ESBL-E. coli strain were also used as reference strains.
Table 1.
Primer sequences, amplicon size, and cycling conditions used for the detection of ESBL resistance genes.
2.10. Data Analysis
Data treatment and statistical analysis were performed using Microsoft Excel version 2016 (Microsoft Ltd., Redmond, WA, USA) and Rstudio version 4.2.2 (R Core Team, Vienna, Austria) [42]. Normal distribution tests were performed using the Shapiro–Wilk test, while the Bartlett test was used to assess variance homogeneity. When the two assumptions are not met, e.g., for the lake’s physico-chemical properties, we used the Kruskal–Wallis test, followed by a Dunn a posteriori test performed with the “dunn.test” package version 1.3.6. Tukey’s post hoc test (emmeans package version 1.11.2) was applied for pairwise comparisons of means. Bacterial community diversity was assessed on the basis of calculations using Shannon–Wiener (H′) ecological indices [43] with the vegan package version 2.7.1. Relationships between lake properties and bacterial abundance and diversity were assessed using Pearson correlation with the stats package version 4.5. All graphs were generated using the “ggplot2” package version 3.5.2 [44]. All data sets on bacterial abundance and lake chemical properties were subjected to principal component analysis (PCA) using the “FactoMineR” (version 2.11) and “factoextra” (version 1.0.7) packages. The relevance of the data for PCA was verified using the Kaiser–Meyer–Olkin (KMO) index. PCA was used to explore the associations between response variables, i.e., chemical properties regarding lakes and bacterial communities.
3. Results
3.1. Sociodemographic Characteristics of Lettuce Producers Around Yamoussoukro Lakes
The survey identified several trends among the interviewed producers (Table 2). About 60% of them were male and between 30 and 45 years old. In terms of farming experience, 35.38% of respondents indicated that they had between 5 and 10 years of experience in market gardening. Furthermore, 81.53% of the farmers were Ivorian. Finally, the level of education was generally low, with 73.84% of growers reporting that they were illiterate, as displayed in Table 2.
Table 2.
Sociodemographic characteristics of market gardeners around four artificial lakes in Yamoussoukro.
3.2. Biocontamination Risk Practices for Lettuce in the Field
Farmers’ daily practices illustrate a pathway toward biocontamination risks (Figure 2). Every day, fields are irrigated exclusively with lake water, used without any prior treatment (Figure 3). All the farmers use chicken manure as their only organic fertilizer, and harvesting equipment is not washed after use. During harvesting, different packaging methods are used. All of the producers use bags to pack the lettuce. Furthermore, 83.07% of them utilize basins, while 10.76% of them place the lettuce directly on the ground. The lettuce harvested in this way is primarily sold at local markets in Yamoussoukro. However, 90.76% of producers indicated that their products are also shipped to other cities, mainly the economic capital, Abidjan. All producers usually consume a part of their own products. In terms of risk perception, 100% of the farmers said they were aware of food-borne infections. However, none of them were aware of antibiotic resistance at the time of the survey.
Figure 2.
Frequency of biocontamination risk practices in lettuce fields.
Figure 3.
View of lettuce crops irrigated with lake water.
3.3. Physicochemical Properties of the Lakes
Significant differences (p-value < 0.05) in the water’s physicochemical properties were observed among the four lakes (Table 3). The total dissolved solids (TDS) levels vary significantly among the lakes, with the highest recorded in lake 5 (2.25 ± 0.06 mg/L) and the lowest recorded in lake 1 (1.44 ± 0.49 mg/L). Conductivity levels differed significantly between lakes, with lake 6 (3.77 ± 0.1 µS/cm) having the highest conductivity and lake 1 (2.41 ± 0.82 µS/cm) having the lowest. Ammonium (NH4+) and bicarbonate (HCO3−) levels were significantly higher in lake 5 (11.82 ± 1.2 and 334 ± 20.9 mg/L, respectively) and lower in lake 1 (0.65 ± 0.41 and 142 ± 50.2 mg/L, respectively). Lake 6 has a high TH with a higher calcium concentration (0.67 ± 0.02 mg/L). Turbidity was significantly higher in lake 8 (216.67 ± 52.08) compared to lake 1, lake 5, and lake 6 (p < 0.001). Lake 8’s water is much more alkaline, with a pH of 8.47 ± 0.55, unlike lake 1, which has a pH that tends towards acidity. The lake temperatures ranged from 22 to 25 °C, with the highest temperature recorded in lake 5 (25.2 ± 0.61). Statistical analysis revealed no significant differences (p-value > 0.05) among the lakes in terms of NO3−, NO2−, PO43−, Mg2+, and dissolved oxygen values.
Table 3.
Physicochemical properties of lakes prospected in Yamoussoukro and their statistical significance.
3.4. Distribution and Diversity of the Bacterial Community in Each Sample
A total of 68 isolates were identified via 16S rDNA sequencing, including 38 from the lake water and 30 from the lettuce. Phylogenetic analysis suggested that they belonged to nine different taxa, with E. coli being the major isolates (>30%) (Figure 4). These taxa were identified at the genus and/or species level, including Escherichia coli (32.35%, n = 22), Acinetobacter spp. (25.37%, n = 17), Citrobacter spp. (16.17%, n = 11), Pseudomonas spp. (11.94%, n = 8), Enterobacter spp. (5.97%, n = 4), Kluyvera georgiana (2.98%, n = 2), Edwardsiella tarda (2.98%, n = 2), Proteus mirabilis (1.49%, n = 1), and Leclercia spp. (1.49%, n = 1).
Figure 4.
Phylogenetic tree of potential pathogenic bacteria isolated from lake waters and lettuce in Yamoussoukro, Côte d’Ivoire, based on 16S rDNA gene sequences. The sequences of the best match reference type strains were collected from GenBank and then aligned using MUSCLE, as implemented in MEGA software version 11, with the isolates’ 16S rDNA edited sequences. A subsequent phylogenetic tree was reconstructed using the neighbor-joining (NJ) and maximum likelihood (ML) methods with a bootstrap value of 1000 replicates. The resulting tree was visualized with iTool.
The Shannon diversity index values were 1.51 and 1.44, respectively, for the lake and lettuce samples. The distribution of the isolates within these two types of environments is presented in Figure 5. In the lake water samples (n = 38), E. coli was the most prevalent (39.47%, n = 15). Acinetobacter isolates were the second most prevalent, pertaining to Acinetobacter baumannii (n = 2), Acinetobacter venetianus (n = 2), Acinetobacter vivianii (n = 2), Acinetobacter junii (n = 1), and Acinetobacter lactucae (n = 1). Pseudomonas isolates were closely related to Pseudomonas aeruginosa (n = 4), Pseudomonas putida (n = 2), and Pseudomonas monteilii (n = 2). The Citrobacter isolates are closely related to Citrobacter werkmanii (n = 1) and Citrobacter freundii (n = 1) (Figure 4).
Figure 5.
Distribution of the potential pathogenic bacteria identified in lake waters and lettuce in Yamoussoukro, Côte d’Ivoire.
In the lettuce samples (n = 30), the most dominant genus was Acinetobacter (30%, n = 9). Acinetobacter isolates are likely to be Acinetobacter soli (n = 8) and Acinetobacter pittii (n = 1). Enterobacter isolates potentially belong to species Enterobacter bugandensis (n = 2) and Enterobacter sichuanensis (n = 2). The Citrobacter isolates were closely related to Citrobacter werkmanii (n = 3), Citrobacter cronae (n = 3), and Citrobacter sp. (n = 1).
3.5. Relationship Between Lake Physicochemical Properties and Bacterial Diversity and Abundance
The Pearson correlation coefficients among bacterial abundance, the Shannon diversity index, and the lakes’ physicochemical properties are shown in Table 4. A significant negative correlation (p < 0.05) was observed between the Shannon diversity index and dissolved oxygen (r = −0.99). In contrast, non-significant negative correlations were detected among the Shannon diversity index, ammonium level (r = −0.64), and calcium level (r = −0.52). In addition, significant positive correlations (p < 0.05) were detected among bacterial abundance, turbidity (r = 0.962), and pH (r = 0.95). Non-significant positive correlations were also observed among bacterial abundance, TDS (r = 0.58), conductivity (r = 0.542), total hardness (r = 0.63), magnesium level (r = 0.85), temperature (r = 0.61), and potential redox (r = 0.78)
Table 4.
Pearson correlation coefficients among bacterial diversity index, abundance, and surveyed lake chemical properties.
Principal component analysis (PCA) was performed to show the relationships between the lakes’ physicochemical properties and bacterial community composition. The first two principal components explained a total of 84.4% of the variance in the data, with PCA1 accounting for 59.4% and PCA2 accounting for 25% (Figure 6). The first axis (PCA1), which explained the largest portion of the variability, showed positive correlations with TDS (r = 0.99), conductivity (r = 0.99), NH4+ (r = 0.95), HCO3− (r = 0.99), Ca2+ (r = 0.97), TH (r = 0.93), temperature (r = 0.96, pH (r = 0.67), dissolved oxygen (r = 0.44), and redox potential (r = 0.02). Lakes with higher values for these parameters tend to cluster on the positive side of PCA1. In contrast, the second axis (PCA2) showed a negative correlation with dissolved oxygen (r = −0.79), conductivity (r = −0.06), NH4+ (r = −0.22), HCO3− (r = −0.02), and Ca2+ (r = −0.15).
Figure 6.
Principal component analysis (PCA) examining the distribution of chemical properties in lakes correlated with the bacterial community. The colored arrows represent the active variables (standardized physicochemical properties and bacterial communities) used to construct the PCA.
Genera Pseudomonas spp., Edwardsiella tarda, Escherichia coli, and Proteus mirabilis are associated with higher levels of turbidity, pH, Mg2+, temperature, TDS, conductivity, and redox potential, as well as with lower levels of dissolved oxygen. Citrobacter spp. was linked to lower values of TDS, conductivity, NH4+, HCO3−, Ca2+, TH, and temperature. As for Acinetobacter spp., it showed an association with higher TDS, conductivity, NH4+, HCO3−, Ca2+, TH, and temperature, as well as lower dissolved oxygen levels.
3.6. Antibiotic Susceptibility Patterns
The results of the antibiogram were used to determine antibiotic resistance (Figure S1). Based on the total number of isolates, ampicillin showed the highest resistance rate (47%), followed by ceftazidime (35.29%) and cefepime (32.35%). Conversely, the antibiotics exhibiting the lowest resistance rates were chloramphenicol (2.9%) and ticarcillin/clavulanic acid, for which no resistance was observed.
More specifically, the distribution of antibiotic resistance for each species/genus isolated from the lake water and lettuce is presented in Figure 7. A significant proportion of E. coli isolates showed resistance to ampicillin (90.9%), cefepime (72.72%), cefotaxime (68.18%), and aztreonam (63.63%). For Citrobacter isolates, resistance to cefoxitin (90.9%) and ampicillin (81.81%) was observed. Enterobacter isolates demonstrated resistance to ciprofloxacin (75%) and cefoxitin (75%). Some Pseudomonas isolates showed resistance to cefepime, ciprofloxacin, and aztreonam at a frequency of 37.5% for each antibiotic. All Kluyvera gergiana isolates demonstrated 100% resistance to imipenem. Acinetobacter isolates showed resistance only to ceftazidime (82.35%). The bacteria Edwardsiella tarda and Proteus mirabilis were highly susceptible to antibiotics. However, 100% resistance was observed in Edwardsiella tarda to gentamicin, as well as in Proteus mirabilis to ampicillin (100%) and amoxicillin/clavulanic acid (100%). Finally, the Leclercia isolate exhibited no resistance to any of the tested antibiotics.
Figure 7.
Antibiotic resistance distribution of potential pathogenic bacteria isolated from lake waters and lettuce in Yamoussoukro, Côte d’Ivoire. n represents the total number of isolates. AMP: ampicillin; CN: gentamicin; IPM: imipenem; FEP: cefepime; CIP: ciprofloxacin; FOX: cefoxitin; ATM: aztreonam; CTX: cefotaxime; C: chloramphenicol; AMC: amoxicillin/clavulanic acid; CAZ: ceftazidime.
3.7. Prevalence and Antibiotic Resistance Genes Among the ESBL Bacteria
β-lactamase production was confirmed by the synergistic effect observed between ceftazidime (30 μg) and amoxicillin/clavulanic acid (20 μg/10 μg) discs (Figure 8a). ESBL prevalence was found to be 22.05% (15/68). All isolates exhibiting this resistance phenotype belonged to the E. coli species. Ten strains were isolated from lake samples, while five were recovered from lettuce samples. All 15 ESBL-E. coli isolates were found to be positive for blaCTX-M gene presence (100%) (Figure 8b). The blaTEM gene was identified in 11 isolates (73.33%), occurring in conjunction with the blaCTX-M gene. The blaSHV gene was not detected.
Figure 8.
(a) Positive ESBL result to double synergy test and (b) PCR product for blaCTX-M and blaTEM gene (b) Lanes 1–3 and 5: blaCTX-M; Lane 4: 1kb DNA ladder; and Lanes 6–8: blaTEM.
3.8. MARI Index of the Lake and Lettuce Samples
Several isolates (38.23%, n = 26) were resistant to more than three classes of antibiotics and were classified as MDR strains. In lake water samples, E. coli and Pseudomonas spp. exhibited five and one MARP patterns, respectively, which ranged from three to seven. Many of these patterns were single. Only three patterns were observed two and four times, as illustrated in Table 5. In lettuce samples, E. coli, Citrobacter spp., and Enterobacter spp. exhibited six, five, and one MARP patterns, respectively ranging from three to nine. Many of these patterns were single, with only one occurring in duplicate. The MAR index (MARI) of all the MDR isolates recovered from lake water ranged from 0.27 to 0.63, and it ranged from 0.27 to 0.81 for those recovered from lettuce samples (Table 5).
Table 5.
Patterns of MAR phenotypes and MAR index of the isolates from lake water and lettuce samples.
4. Discussion
This study evaluated the genetic diversity, antibiotic resistance profiles, and potential public health implications of 68 Gram-negative bacteria recovered from lake water and lettuce in Yamoussoukro, Côte d’Ivoire, in addition to screening for ESBL production.
First, the physicochemical parameters of the lakes were assessed. The measured physicochemical parameters provide information on the quality of the lake waters. Water temperature and pH differed significantly among the lakes (p < 0.001). Lake 1 was the coolest (22.83 ± 0.55 °C), with a more acidic pH (5.96 ± 0.4), compared to lakes 5, 6, and 8, which were warmer, with a neutral to basic pH. Similarly, bicarbonate ion values differed statistically, with lake 1 showing a lower value (142 ± 50.2 mg/L) compared to the other lakes. These results are consistent with Anoman et al., 2019 [21], who also observed that lake 1 had a lower temperature and pH compared to the other lakes. However, the values remain within the normal range for water used for agriculture [45]. Dissolved oxygen concentrations varied from 4.47 ± 0.35 mgO2/L in lake 8 to 5.87 ± 1.19 mgO2/L in lake 5 and did not show statistically significant differences between the lakes. According to the guidelines, the required concentration of dissolved oxygen is 6 mg/L for drinking water and 4–6 mg/L for fish and domesticated animals [46,47]. Thus, the observed values indicate that the lakes are well oxygenated. Water hardness reflects the geological nature of the area with which the water has been in contact [48]. The major cations causing water hardness are Ca2+ and Mg2+. In this study, values obtained for Ca2+ ranged from 0.41 ± 0.04 mg/L (lake 1) to 0.67 ± 0.02 mg/L (lake 6) and differed statistically from one lake to another. The same is true of the TH value (range from 0.54 ± 0.13 mg/L to 0.9 ± 0.06 mg/L), while on the other hand, the values for Mg2+ are not statistically different (range from 0.13 ± 0.1 mg/L to 0.23 ± 0.05 mg/L). According to the classification system proposed by Sawyer et al. (2003) [49], which categorizes water as soft (<75 mg/L), moderately hard (75–150 mg/L), hard (150–300 mg/L), and very hard (>300 mg/L), the lake water can be classified as soft. Conductivity and TDS values were in agreement: very low, with statistically significant differences among the lakes. These two parameters are correlated and indicate the salinity level in water [50]. The values obtained in this study meet the permissible value for agricultural water [45]. Values for turbidity range from 7 ± 5.26 NTU to 216.67 ± 52.08 NTU, with statistically significant differences among the lakes. Except for lake 1, all the lakes exceed the permissible value [47,51]. Turbidity is a key water quality parameter for drinking water due to its link with pathogenic microorganisms. Thus, the indication is that waters with higher turbidity values could be sources of water-borne diseases [48]. Nitrate, nitrite, and phosphorus values did not show any statistically significant differences among the lakes, despite numerical variations, unlike the values for ammonium, for which the difference was significant (p < 0.001). The concentration of nutrients, primarily nitrogen and phosphorus compounds, can compromise water quality [52]. As a result, excessive nutrient input into an aquatic system leads to eutrophication, a biological response that results in adverse effects such as poor water quality, which in turn restricts its use in industry and agriculture [52,53]. These findings are consistent with authors who describe the artificial lakes of Yamoussoukro as eutrophic [21,23,54,55]. Human activities within the watershed and surrounding areas have led to this phenomenon, as the lakes receive significant amounts of pollutants, including erosion products, domestic waste, oil, and untreated sewage [54].
Then, bacterial isolates were identified as members of the Acinetobacter, Citrobacter, Escherichia, Enterobacter, Pseudomonas, Kluyvera, Leclercia, Edwardsiella, and Proteus genera. These isolates were dominated by E. coli at the species level in terms of relative abundance, but the genetic variability was more important in the genus Acinetobacter. About seven species of Acinetobacter were identified, including Acinetobacter baumanii, A. junii, A. lactucae, A. pittii, A. soli, A. vivianii, and A. venetianus. The presence of pathogenic bacteria in water systems and lettuce has been documented in numerous studies, with the incidence of such bacteria most often associated with human infections [15,56,57,58,59]. Additionally, some species have been linked to issues in aquaculture [60]. The identification of Gram-negative bacteria from both Yamoussoukro Lake and surrounding lettuce samples highlights the potential public health risks associated with environmental and food contamination.
The impact of the lake’s physicochemical parameters on the bacterial community (diversity and abundance) was assessed using Pearson correlation. Both positive and negative correlations were obtained; however, they were significant for only three parameters overall. Specifically, dissolved oxygen emerged as a determinant for bacterial diversity, showing a strong negative correlation. This result aligns with Anoman et al., 2019 [21]. As a fundamental and often limiting resource, dissolved oxygen is essential for the respiration of the vast majority of aquatic organisms, which includes a broad spectrum of bacterial species [61]. Obligate aerobes require high oxygen concentrations for optimal growth, while microaerophiles thrive in much lower concentrations. Facultative anaerobes can use oxygen if available but can also grow without it, whereas aerotolerant anaerobes do not use oxygen for growth but can survive in its presence [62]. This would impose selective pressure, where even marginal decreases in dissolved oxygen levels would be associated with a drastic reduction in bacterial diversity within the lake ecosystem. Furthermore, bacterial abundance was found to be significantly and positively correlated with both turbidity and pH. Studies have explicitly shown that increased concentrations of suspended solids can significantly enhance bacterial production and abundance [63,64]. High turbidity is often associated with indicators of water quality degradation, such as an increase in organic matter load, soil erosion, or dense algal blooms, all of which provide substrates and conditions conducive to bacterial proliferation [48]. Similar to turbidity, a high pH leads to an increase in biodegradable organic matter in the water, especially during the dry season, which favors the growth of microbial populations [61].
The genus Acinetobacter comprises a heterogeneous group of non-fermentative Gram-negative bacteria. They have recently become a focus of attention for scientists and clinicians, in terms of both their fundamental biological properties and their pathogenic potential [65]. In this study, Acinetobacter soli was the most prevalent of the lettuce isolates (>88%), contrasting with previous reports that identified A. calcoaceticus and A. johnsonii as the most common [66] A. soli was recently associated with invasive infection in Japan [67]. In the lakes, Acinetobacter species were more diverse, with A. baumanii, A. vivianii, A. venetianus, A. junii, and A. lactucae being identified. This result is in line with several previous studies and further highlights water as a reservoir of Acinetobacter species. However, data showing the existence of these species in aquatic environments is not a novel phenomenon [68,69,70]. Nevertheless, this finding is a matter of concern, particularly given the role of species such as A. baumanii in causing a significant number of human infections and, consequently, representing a public health risk [65]. Acinetobacter spp. have also been identified as a significant concern in terms of antibiotic resistance [66,67,69,70]. Resistances observed in this study were only to ceftazidime (82.35%), and no EBSL producers were detected. Thus, the mechanism of resistance observed was likely due to the production of chromosomal enzyme AmpC cephalosporinases, which confer resistance to broad-spectrum cephalosporins [71]. Moreover, the use of media containing ceftazidime might have facilitated the isolation of resistant strains.
It was expected that an important number of species from the order Enterobacterales would be present in both areas, given that these microorganisms constitute the largest Gram-negative family [3,58]. In the lake sample, the isolated species included Escherichia coli, Citrobacter werkmanii, C. freundii, Edwardsiella tarda, and Proteus mirabilis. While in the lettuce sample, the species included C. werkmanii, C. cronae, E. coli, Enterobacter bugandensis, Enterobacter sichuanensis, Kluyvera georgiana, and Leclercia spp. The presence of E. coli in the Yamoussoukro lakes and on the vegetables was previously evaluated, as well as antibiotic resistance to some antibiotics [21,22], lending support to the current findings. However, we reported the presence of other species from the order Enterobacterales, which increase the concern. In Iran, a foodborne outbreak was attributed to the bacterium Citrobacter freundii, with environmental factors identified as a contributing element in the contamination [72]. A further report has identified Edwardsiella tarda as a significant cause of concern, particularly in relation to its potential to cause severe food- and waterborne infections, with a high mortality rate among patients with underlying liver cirrhosis [73]. Thus, the order Enterobacterales encompasses both waterborne and foodborne species, reflecting the elevated level of contamination observed in these environments [74].
Moreover, the majority of antibiotic resistance observed in this study was confined to the order Enterobacterales. Citrobacter spp. exhibited resistance to cefoxitin (90.9%) and ampicillin (81.8%), and Enterobacter spp. demonstrated resistance to cefoxitin (75%), as they are naturally resistant to these antibiotics [75]. However, resistance to imipenem was also observed in 45.45% of Citrobacter spp. and 50% of Enterobacter spp. Additionally, imipenem resistance was observed in multiresistant strains from these genera. These findings are in accordance with those reported by Duran-Bedolla et al. [76]. Resistance to imipenem is frequently an indicator of carbapenemase multiresistance [77]. Concomitantly, Kluyvera georgiana also exhibited resistance to imipenem (50%), which aligns with recent studies describing its acquired resistance to carbapenems [78,79]. Therefore, further testing is required to confirm the presence of this multiresistance in the isolate in question.
The E. coli isolates demonstrated resistance to the majority of antibiotics tested, with a particularly high prevalence to ampicillin (90.9%), cefepime (72.72%), cefotaxime (68.18%), and aztreonam (63.63%). These findings align with those of Anokyewaa Appau et al. [80] in Ghana. The potential role of water as a reservoir for pathogenic E. coli has been documented in prior research [16,80,81]. It can reasonably be assumed that contamination of vegetables will occur during the process of irrigation. The isolate demonstrated multidrug resistance through the production of an extended-spectrum beta-lactamase, with blaCTX-M being the most dominant gene. Additionally, the blaTEM gene was identified in certain strains (73.33%). Initially identified in the E. coli species, this gene primarily mediates chromosomal resistance [6], although it can also be carried by plasmids. In contrast, the blaCTX-M gene is plasmid-mediated [6]. This genomic location facilitated the dissemination of the gene in a variety of environments. Furthermore, plasmids carrying the blaCTX-M gene have the capacity to harbor resistance genes to additional antibiotic classes [82], thereby intensifying the threat and public health risk associated with this resistance.
Pseudomonas spp. comprises a diverse range of species that are ubiquitous in various environmental niches, including soil, water, plants, food, and sewage. The Pseudomonas strains isolated in this study include P. aeruginosa, P. putida, and P. monteilii. These organisms are opportunistic pathogens that can cause serious infections in people with a weakened immune system. Among these species, P. aeruginosa stands out the most and is frequently associated with nosocomial infections [83,84] and drinking water contamination [85,86]. However, P. monteilii and P. putida have been reported to be associated with infections in humans [87,88]. Furthermore, Pseudomonas spp. exhibits high resistance, limiting the number of remaining antibiotics that can be utilized in treatment. In this study, multiresistant strains were obtained with a MAR phenotype pattern of “FEP-CIP-IPM.” Like Citrobacter spp. and Enterobacter spp., it is possible that these isolates exhibit carbapenemase resistance. Pseudomonas spp. carbapenemase-resistant bacteria have been identified as a significant public health concern by the WHO [5,89]. Therefore, this mechanism should be assessed in isolated samples to determine its prevalence.
The MAR phenotypes compiled for all the isolates indicated a high degree of multiple antibiotic resistance, with a range of resistance to three to nine antibiotics. The most prevalent MARPs observed included “AMP-FEP-ATM-CTX” and “AMP-FEP-ATM-CTX-AMC-CAZ,” which collectively represented 22.22% of the MARPs observed in the isolates. This suggests that the combination of these antibiotics may prove ineffective in treating human or animal infections [90]. Additionally, the MARP “AMP-FEP-ATM-CTX” was identified in both lake and lettuce isolates. However, due to the limitations of phenotypic analysis, it is challenging to infer the transmission of resistance with the same degree of accuracy as genotyping. The potential health risks associated with the dissemination of antibiotic resistance in an environmental setting are estimated using MARI [37,91]. A MARI value of 0.2 was employed to differentiate between low and high health risks. A value exceeding 0.2 indicates that the multiresistant isolates likely originated from an environment with high contamination or the overuse of antibiotics [37,90,91]. In this study, the MARI values obtained, predominantly ≥0.2, indicate an overuse or misuse of antibiotics in the environmental context from which the samples were collected. This could potentially lead to an increased transmission of MDR isolates to humans via the consumption of contaminated vegetables or direct contact with lake waters.
The daily use of lake water for irrigation is very common for farmers (100% of the surveyed producers), although it represents a continuous influx of potential hazards [19]. The results of this study showed that the manmade lakes of Yamoussoukro are suitable for irrigation. However, for human health, it is important to consider the high level of turbidity, eutrophication, opportunistic pathogenic bacteria, and antibiotic resistance, as discussed above. Thus, the lakes become reservoirs of contaminants, creating a cycle in which irrigation perpetuates the contamination of the food system [56]. Simultaneously, the use of chicken manure as fertilizer (used by 100% of the surveyed producers), especially when untreated, is a well-documented source of foodborne pathogens and is associated with ESBL resistance [80,92,93]. Consequently, solutions for water and lettuce quality in the Yamoussoukro area must be integrated into the “One Health” concept, where environmental health impacts human health through the food supply. Although farmers understand the general concept of foodborne illness, their complete lack of awareness of antibiotic resistance means that they are inadvertently contributing to a major global health crisis through their practices. Given this observation, it would be beneficial to implement training programs on good agricultural and hygiene practices, as well as awareness campaigns on antibiotic resistance, for lettuce producers.
5. Conclusions
Gram-negative bacteria represent a significant source of antimicrobial resistance. The findings of this study provide critical insights into the potential public health risks associated with their presence in both Yamoussoukro’s lakes and the lettuce grown in the area. The identification of a wide range of bacterial genera, including known pathogens, coupled with a high prevalence of antibiotic resistance and a MARI exceeding the threshold, highlights an urgent threat to public health. The presence of ESBL-producing E. coli and other multidrug-resistant isolates further underscores the need for immediate monitoring and intervention.
Future research should focus on larger-scale investigations that encompass source tracking of resistance genes, in-depth genomic characterization of the isolates (whole genome sequencing), and a more detailed analysis of the impact of agricultural practices and lake water quality on the dissemination of antibiotic resistance. These efforts are crucial for developing effective surveillance and intervention strategies to mitigate the spread of antibiotic-resistant bacteria and protect public health in Côte d’Ivoire.
Supplementary Materials
The following supporting information can be downloaded at https://www.mdpi.com/article/10.3390/microorganisms13091997/s1: Figure S1. Antibiogram of one resistant isolate. Table S1. Breakpoint used for the interpretation of the inhibition value. Table S2. Isolates analyzed in this study and their accession numbers for the 16S rDNA gene.
Author Contributions
Conceptualization, A.C.I.Y., K.R.F., and A.Z.; methodology, A.C.I.Y.; validation, K.R.F., A.I.O., and A.Z.; investigation, A.C.I.Y.; data curation, A.C.I.Y.; writing—original draft preparation, A.C.I.Y.; writing—review and editing, K.R.F., Z.G.C.K.-Z., A.I.O., and A.Z.; supervision, A.Z.; funding acquisition, A.C.I.Y., K.R.F., Z.G.C.K.-Z., A.I.O., and A.Z. All authors have read and agreed to the published version of the manuscript.
Funding
This research was funded by the South African Medical Research Council (SAMRC-UFH/P790) and the Union Économique et Monétaire Ouest-Africaine (UEMOA) through the scholarship program for training and research edition 2022–2025.
Institutional Review Board Statement
Not applicable.
Informed Consent Statement
Not applicable.
Data Availability Statement
The original contributions presented in this study are included in the article/Supplementary Materials. Further inquiries can be directed to the corresponding authors.
Acknowledgments
We would like to acknowledge the South African Medical Research Council for funding support. We are also grateful to UEMOA for the 3-year Ph.D. scholarship generously provided to A.C.I.Y.
Conflicts of Interest
The authors declare no conflicts of interest.
References
- Neyen, C.; Lemaitre, B. Sensing Gram-Negative Bacteria: A Phylogenetic Perspective. Curr. Opin. Immunol. 2016, 38, 8–17. [Google Scholar] [CrossRef]
- Silhavy, T.J.; Kahne, D.; Walker, S. The Bacterial Cell Envelope. Cold Spring Harb. Perspect. Biol. 2010, 2, a000414. [Google Scholar] [CrossRef]
- Oliveira, J.; Reygaert, W.C. Gram Negative Bacteria. In StatPearls; StatPearls Publishing: Treasure Island, FL, USA, 2022. [Google Scholar]
- Gauba, A.; Rahman, K.M. Evaluation of Antibiotic Resistance Mechanisms in Gram-Negative Bacteria. Antibiotics 2023, 12, 1590. [Google Scholar] [CrossRef]
- WHO. WHO Publishes List of Bacteria for Which New Antibiotics Are Urgently Needed. Available online: https://www.who.int/news/item/27-02-2017-who-publishes-list-of-bacteria-for-which-new-antibiotics-are-urgently-needed (accessed on 20 June 2023).
- Bonomo, R.A. β-Lactamases: A Focus on Current Challenges. Cold Spring Harb. Perspect. Med. 2017, 7, a025239. [Google Scholar] [CrossRef]
- Islam, K.; Heffernan, A.J.; Naicker, S.; Henderson, A.; Chowdhury, M.A.H.; Roberts, J.A.; Sime, F.B. Epidemiology of Extended-Spectrum β-Lactamase and Metallo-β-Lactamase-Producing Escherichia Coli in South Asia. Future Microbiol. 2021, 16, 521–535. [Google Scholar] [CrossRef]
- Kiros, T.; Workineh, L.; Tiruneh, T.; Eyayu, T.; Damtie, S.; Belete, D. Prevalence of Extended-Spectrum β-Lactamase-Producing Enterobacteriaceae in Ethiopia: A Systematic Review and Meta-Analysis. Int. J. Microbiol. 2021, 2021, 6669778. [Google Scholar] [CrossRef]
- Wilson, H.; Török, M.E. Extended-Spectrum β-Lactamase-Producing and Carbapenemase-Producing Enterobacteriaceae. Microb. Genom. 2018, 4, e000197. [Google Scholar] [CrossRef]
- Stephens, P.R.; Gottdenker, N.; Schatz, A.M.; Schmidt, J.P.; Drake, J.M. Characteristics of the 100 Largest Modern Zoonotic Disease Outbreaks. Philos. Trans. R. Soc. B Biol. Sci. 2021, 376, 20200535. [Google Scholar] [CrossRef] [PubMed]
- Zhang, Y.; Li, J.; Wu, T.; Ma, K.; Cheng, Z.; Yi, Q.; Dai, Y.; Wang, B.; Chen, Y.; Wang, B.; et al. Characteristics of Antibiotic Resistance Genes and Microbial Community Distribution in Wanfeng Lake, Upper Pearl River, China. Environ. Sci. Pollut. Res. 2023, 30, 83214–83230. [Google Scholar] [CrossRef] [PubMed]
- Fouz, N.; Pangesti, K.N.A.; Yasir, M.; Al-Malki, A.L.; Azhar, E.I.; Hill-Cawthorne, G.A.; Abd El Ghany, M. The Contribution of Wastewater to the Transmission of Antimicrobial Resistance in the Environment: Implications of Mass Gathering Settings. Trop. Med. Infect. Dis. 2020, 5, 33. [Google Scholar] [CrossRef] [PubMed]
- Zaatout, N.; Bouras, S.; Slimani, N. Prevalence of Extended-Spectrum β-Lactamase (ESBL)-Producing Enterobacteriaceae in Wastewater: A Systematic Review and Meta-Analysis. J. Water Health 2021, 19, 705–723. [Google Scholar] [CrossRef]
- Cho, S.; Jackson, C.R.; Frye, J.G. Freshwater Environment as a Reservoir of Extended-Spectrum β-Lactamase-Producing Enterobacteriaceae. J. Appl. Microbiol. 2023, 134, lxad034. [Google Scholar] [CrossRef]
- Iwu, C.D.; du Plessis, E.M.; Korsten, L.; Nontongana, N.; Okoh, A.I. Antibiogram Signatures of Some Enterobacteria Recovered from Irrigation Water and Agricultural Soil in Two District Municipalities of South Africa. Microorganisms 2020, 8, 1206. [Google Scholar] [CrossRef]
- Quarcoo, G.; Boamah Adomako, L.A.; Abrahamyan, A.; Armoo, S.; Sylverken, A.A.; Addo, M.G.; Alaverdyan, S.; Jessani, N.S.; Harries, A.D.; Ahmed, H.; et al. What Is in the Salad? Escherichia Coli and Antibiotic Resistance in Lettuce Irrigated with Various Water Sources in Ghana. Int. J. Environ. Res. Public. Health 2022, 19, 12722. [Google Scholar] [CrossRef]
- Liao, N.; Borges, C.A.; Rubin, J.; Hu, Y.; Ramirez, H.A.; Chen, J.; Zhou, B.; Zhang, Y.; Zhang, R.; Jiang, J.; et al. Prevalence of β-Lactam Drug-Resistance Genes in Escherichia Coli Contaminating Ready-to-Eat Lettuce. Foodborne Pathog. Dis. 2020, 17, 739–742. [Google Scholar] [CrossRef]
- Richter, L.; Du Plessis, E.M.; Duvenage, S.; Korsten, L. Occurrence, Identification, and Antimicrobial Resistance Profiles of Extended-Spectrum and AmpC β-Lactamase-Producing Enterobacteriaceae from Fresh Vegetables Retailed in Gauteng Province, South Africa. Foodborne Pathog. Dis. 2019, 16, 421–427. [Google Scholar] [CrossRef] [PubMed]
- Gekenidis, M.-T.; Rigotti, S.; Hummerjohann, J.; Walsh, F.; Drissner, D. Long-Term Persistence of blaCTX-M-15 in Soil and Lettuce after Introducing Extended-Spectrum β-Lactamase (ESBL)-Producing Escherichia Coli via Manure or Water. Microorganisms 2020, 8, 1646. [Google Scholar] [CrossRef] [PubMed]
- Tano, B.; Abo, K.; Dembele, A.; Fondio, L. Systèmes de Production et Pratiques à Risque En Agriculture Urbaine: Cas Du Maraîchage Dans La Ville de Yamoussoukro En Côte d’Ivoire. Int. J. Biol. Chem. Sci. 2012, 5, 2317–2329. [Google Scholar] [CrossRef]
- Anoman, T.M.; Voko, D.-R.R.B.; Zézé, A. Spatial and Temporal Dynamics of Coliform Contamination within Yamoussoukro Lake Waters in Côte d’Ivoire: Impact on the Safety of Surrounding Vegetable Cropping. Microbiol. Nat. 2019, 1, 29–43. [Google Scholar]
- Anoman, T.M.; Voko, D.-R.R.B.; Doga, D.; Kouadio, A.N.M.S.; Ahoudjo, K.S.; Zeze, A. Monitoring the Influence of Anthropogenic Pollution on the Quality of Irrigation Water for Market Gardening in Yamoussoukro, Côte d’Ivoire. Indian J. Agric. Res. 2021, 55, 715–720. [Google Scholar] [CrossRef]
- Kouamé, P.K.; Nguyen-Viet, H.; Dongo, K.; Zurbrügg, C.; Biémi, J.; Bonfoh, B. Microbiological Risk Infection Assessment Using QMRA in Agriculture Systems in Côte d’Ivoire, West Africa. Environ. Monit. Assess. 2017, 189, 587. [Google Scholar] [CrossRef]
- Ministère du Développement Durable, de l’Environnement, de la Faune et des Parcs (MDDEFP). Guide Pour L’évaluation de La Qualité Bactériologique de L’eau En Lac; Direction du Suivi de L’état de L’environnement: Quebec, QC, Canada, 2013; ISBN 978-2-550-67327-9. Available online: https://www.environnement.gouv.qc.ca/publications/2013/env20130509.htm (accessed on 30 September 2021).
- AFNOR. Qualité de L’eau: Environnement Recueil de Normes Françaises; Association Française de Normalisation, Ed.; AFNOR: Paris-La Défense, France, 1994; ISBN 978-2-12-179011-4. [Google Scholar]
- Rawat, S.; Joshi, G.; Annapurna, D.; Arunkumar, A.N.; Karaba, N.N. Standardization of DNA Extraction Method from Mature Dried Leaves and ISSR-PCR Conditions for Melia Dubia Cav.—A Fast Growing Multipurpose Tree Species. Am. J. Plant Sci. 2016, 7, 437–445. [Google Scholar] [CrossRef]
- Tamura, K.; Stecher, G.; Kumar, S. MEGA11: Molecular Evolutionary Genetics Analysis Version 11. Mol. Biol. Evol. 2021, 38, 3022–3027. [Google Scholar] [CrossRef]
- Saitou, N.; Nei, M. The Neighbor-Joining Method: A New Method for Reconstructing Phylogenetic Trees. Mol. Biol. Evol. 1987, 24, 189–204. [Google Scholar] [CrossRef]
- Rogers, J.; Swofford, D. A Fast Method for Approximating Maximum Likelihoods of Phylogenetic Trees from Nucleotide Sequences. Syst. Biol. 1998, 47, 77–89. [Google Scholar] [CrossRef]
- Felsenstein, J. Confidence Limits on Phylogenies: An Approach Using the Bootstrap. Evolution 1985, 39, 783–791. [Google Scholar] [CrossRef] [PubMed]
- Letunic, I.; Bork, P. Interactive Tree of Life (iTOL) v5: An Online Tool for Phylogenetic Tree Display and Annotation. Nucleic Acids Res. 2021, 49, W293–W296. [Google Scholar] [CrossRef]
- Bauer, A.W.; Kirby, W.M.M.; Sherris, J.C.; Turck, M. Antibiotic Susceptibility Testing by a Standardized Single Disk Method. Am. J. Clin. Pathol. 1966, 45, 493–496. [Google Scholar] [CrossRef] [PubMed]
- Société Française de Microbiologie. Tableaux des concentrations critiques pour l’interprétation des CMI et des diamètres critiques des zones d’inhibition. In CA-SFM/EUCAST: Société Française de Microbiologie; Société Française de Microbiologie: Paris, France, 2025; pp. 47–63. Available online: https://www.sfm-microbiologie.org/boutique/_comite-de-lantibiogramme-de-la-sfm-ca-sfm-v1-1-juilet-2025/ (accessed on 10 July 2025).
- Drieux, L.; Brossier, F.; Sougakoff, W.; Jarlier, V. Phenotypic Detection of Extended-Spectrum Beta-Lactamase Production in Enterobacteriaceae: Review and Bench Guide. Clin. Microbiol. Infect. 2008, 14 (Suppl. S1), 90–103. [Google Scholar] [CrossRef] [PubMed]
- Jarlier, V.; Nicolas, M.-H.; Fournier, G.; Philippon, A. Extended Broad-Spectrum -Lactamases Conferring Transferable Resistance to Newer -Lactam Agents in Enterobacteriaceae: Hospital Prevalence and Susceptibility Patterns. Clin. Infect. Dis. 1988, 10, 867–878. [Google Scholar] [CrossRef]
- Magiorakos, A.-P.; Srinivasan, A.; Carey, R.B.; Carmeli, Y.; Falagas, M.E.; Giske, C.G.; Harbarth, S.; Hindler, J.F.; Kahlmeter, G.; Olsson-Liljequist, B.; et al. Multidrug-Resistant, Extensively Drug-Resistant and Pandrug-Resistant Bacteria: An International Expert Proposal for Interim Standard Definitions for Acquired Resistance. Clin. Microbiol. Infect. 2011, 18, 268–281. [Google Scholar] [CrossRef]
- Titilawo, Y.; Sibanda, T.; Obi, L.; Okoh, A. Multiple Antibiotic Resistance Indexing of Escherichia Coli to Identify High-Risk Sources of Faecal Contamination of Water. Environ. Sci. Pollut. Res. 2015, 22, 10969–10980. [Google Scholar] [CrossRef] [PubMed]
- Krumperman, P.H. Multiple Antibiotic Resistance Indexing of Escherichia Coli to Identify High-Risk Sources of Fecal Contamination of Foods. Appl. Environ. Microbiol. 1983, 46, 165–170. [Google Scholar] [CrossRef] [PubMed]
- Olesen, I.; Hasman, H.; Aarestrup, F.M. Prevalence of Beta-Lactamases among Ampicillin-Resistant Escherichia Coli and Salmonella Isolated from Food Animals in Denmark. Microb. Drug Resist. Larchmt. N 2004, 10, 334–340. [Google Scholar] [CrossRef]
- Arlet, G.; Rouveau, M.; Philippon, A. Substitution of Alanine for Aspartate at Position 179 in the SHV-6 Extended-Spectrum β-Lactamase. FEMS Microbiol. Lett. 1997, 152, 163–167. [Google Scholar] [CrossRef]
- Hasman, H.; Mevius, D.; Veldman, K.; Olesen, I.; Aarestrup, F.M. β-Lactamases among Extended-Spectrum β-Lactamase (ESBL)-Resistant Salmonella from Poultry, Poultry Products and Human Patients in The Netherlands. J. Antimicrob. Chemother. 2005, 56, 115–121. [Google Scholar] [CrossRef]
- Krotov, V. A Quick Introduction to R and RStudio. 2017. Available online: https://www.researchgate.net/publication/321111041_A_Quick_Introduction_to_R_and_RStudio?channel=doi&linkId=5a0e121faca27244d2858844&showFulltext=true (accessed on 18 August 2025). [CrossRef]
- Shannon, C.E. A Mathematical Theory of Communication. Bell Syst. Tech. J. 1948, 27, 379–423. [Google Scholar] [CrossRef]
- Wickham, H. Ggplot2: Elegant Graphics for Data Analysis; Springer: New York, NY, USA, 2009; ISBN 978-0-387-98140-6. [Google Scholar]
- Ayers, R.S.; Westcot, D.W. Water Quality for Agriculture; FAO irrigation and drainage paper; Food and Agriculture Organization of the UN: Rome, Italy, 1985; ISBN 978-92-5-102263-4. [Google Scholar]
- WHO. Guidelines for Drinking-Water Quality. 1: Recommendations; World Health Organization: Geneva, Switzerland, 2004; ISBN 978-92-4-154638-6. [Google Scholar]
- DoE. Environment Conservation Rules; Department of Environment of Ministry of Environment and Forest of Bangladesh: Dhaka, Bangladesh, 1997. [Google Scholar]
- Ugbaja, A.N.; Ephraim, B.E. Physicochemical and Bacteriological Parameters of Surface Water Quality in Part of Oban Massif, Nigeria. Glob. J. Geol. Sci. 2019, 17, 13–24. [Google Scholar] [CrossRef]
- Sawyer, C.N.; McCarty, P.L.; Parkin, G.F. Chemistry for Environmental Engineers, 5th ed.; McGraw-Hill: New York, NY, USA, 2003. [Google Scholar]
- Rusydi, A.F. Correlation between Conductivity and Total Dissolved Solid in Various Type of Water: A Review. IOP Conf. Ser. Earth Environ. Sci. 2018, 118, 012019. [Google Scholar] [CrossRef]
- Rahman, A.; Jahanara, I.; Jolly, Y.N. Assessment of Physicochemical Properties of Water and Their Seasonal Variation in an Urban River in Bangladesh. Water Sci. Eng. 2021, 14, 139–148. [Google Scholar] [CrossRef]
- Savic, R.; Stajic, M.; Blagojević, B.; Bezdan, A.; Vranesevic, M.; Nikolić Jokanović, V.; Baumgertel, A.; Bubalo Kovačić, M.; Horvatinec, J.; Ondrasek, G. Nitrogen and Phosphorus Concentrations and Their Ratios as Indicators of Water Quality and Eutrophication of the Hydro-System Danube–Tisza–Danube. Agriculture 2022, 12, 935. [Google Scholar] [CrossRef]
- Han, F.; Tian, Q.; Chen, N.; Hu, Z.; Wang, Y.; Xiong, R.; Xu, P.; Liu, W.; Stehr, A.; Barra, R.O.; et al. Assessing Ammonium Pollution and Mitigation Measures through a Modified Watershed Non-Point Source Model. Water Res. 2024, 254, 121372. [Google Scholar] [CrossRef] [PubMed]
- N’Guessan, K.A.; Konan, K.F.; Bony, K.Y.; Edia, O.E.; Gnagne, T.; Traore, K.S.; Houenou, P.V. Prospects for Rehabilitation of Man-Made Lake System of Yamoussoukro (Ivory Coast). Procedia Environ. Sci. 2011, 9, 140–147. [Google Scholar] [CrossRef]
- Sadat, A.; N’Goran, E.B.Z.; Siaka, S.; Parinet, B. Intérêt de l’analyse Multidimensionnelle Pour l’évaluation de La Qualité Physico-Chimique de l’eau d’un Système Lacustre Tropical: Cas Des Lacs de Yamoussoukro (Côte d’Ivoire). J. Appl. Biosci. 2011, 38, 2573–2585. [Google Scholar]
- Akinde, S.B.; Sunday, A.A.; Adeyemi, F.M.; Fakayode, I.B.; Oluwajide, O.O.; Adebunmi, A.A.; Oloke, J.K.; Adebooye, C.O. Microbes in Irrigation Water and Fresh Vegetables: Potential Pathogenic Bacteria Assessment and Implications for Food Safety. Appl. Biosaf. 2016, 21, 89–97. [Google Scholar] [CrossRef]
- Meier, H.; Spinner, K.; Crump, L.; Kuenzli, E.; Schuepbach, G.; Zinsstag, J. State of Knowledge on the Acquisition, Diversity, Interspecies Attribution and Spread of Antimicrobial Resistance between Humans, Animals and the Environment: A Systematic Review. Antibiotics 2023, 12, 73. [Google Scholar] [CrossRef] [PubMed]
- Reche, M.H.L.R.; Reali, C.; Pittol, M.; De Athayde Saul, D.; Macedo, V.R.M.; Valiati, V.H.; Machado, V.; Fiuza, L.M. Diversity of Culturable Gram-Negative Bacteria Isolated from Irrigation Water of Two Rice Crop Regions in Southern Brazil. Environ. Monit. Assess. 2016, 188, 359. [Google Scholar] [CrossRef]
- Yu, Y.-C.; Yum, S.-J.; Jeon, D.-Y.; Jeong, H.-G. Analysis of the Microbiota on Lettuce (Lactuca Sativa L.) Cultivated in South Korea to Identify Foodborne Pathogens. J. Microbiol. Biotechnol. 2018, 28, 1318–1331. [Google Scholar] [CrossRef]
- Huang, X.; Gu, Y.; Zhou, H.; Xu, L.; Cao, H.; Gai, C. Acinetobacter Venetianus, a Potential Pathogen of Red Leg Disease in Freshwater-Cultured Whiteleg Shrimp Penaeus Vannamei. Aquac. Rep. 2020, 18, 100543. [Google Scholar] [CrossRef]
- Adesakin, T.A.; Oyewale, A.T.; Bayero, U.; Mohammed, A.N.; Aduwo, I.A.; Ahmed, P.Z.; Abubakar, N.D.; Barje, I.B. Assessment of Bacteriological Quality and Physico-Chemical Parameters of Domestic Water Sources in Samaru Community, Zaria, Northwest Nigeria. Heliyon 2020, 6, e04773. [Google Scholar] [CrossRef]
- Morris, R.L.; Schmidt, T.M. Shallow Breathing: Bacterial Life at Low O2. Nat. Rev. Microbiol. 2013, 11, 205–212. [Google Scholar] [CrossRef]
- Steadmon, M.; Ngiraklang, K.; Nagata, M.; Masga, K.; Frank, K.L. Effects of Water Turbidity on the Survival of Staphylococcus Aureus in Environmental Fresh and Brackish Waters. Water Environ. Res. 2023, 95, e10923. [Google Scholar] [CrossRef] [PubMed]
- Hassard, F.; Andrews, A.; Jones, D.L.; Parsons, L.; Jones, V.; Cox, B.A.; Daldorph, P.; Brett, H.; McDonald, J.E.; Malham, S.K. Physicochemical Factors Influence the Abundance and Culturability of Human Enteric Pathogens and Fecal Indicator Organisms in Estuarine Water and Sediment. Front. Microbiol. 2017, 8, 1996. [Google Scholar] [CrossRef] [PubMed]
- Visca, P.; Seifert, H.; Towner, K.J. Acinetobacter Infection—An Emerging Threat to Human Health. IUBMB Life 2011, 63, 1048–1054. [Google Scholar] [CrossRef]
- Carvalheira, A.; Silva, J.; Teixeira, P. Lettuce and Fruits as a Source of Multidrug Resistant Acinetobacter spp. Food Microbiol. 2017, 64, 119–125. [Google Scholar] [CrossRef]
- Kitanaka, H.; Sasano, M.; Yokoyama, S.; Suzuki, M.; Jin, W.; Inayoshi, M.; Hori, M.; Wachino, J.; Kimura, K.; Yamada, K.; et al. Invasive Infection Caused by Carbapenem-Resistant Acinetobacter Soli, Japan. Emerg. Infect. Dis. 2014, 20, 1574–1576. [Google Scholar] [CrossRef] [PubMed]
- Adewoyin, M.A.; Okoh, A.I. The Natural Environment as a Reservoir of Pathogenic and Non-Pathogenic Acinetobacter Species. Rev. Environ. Health 2018, 33, 265–272. [Google Scholar] [CrossRef]
- Costa-Ribeiro, A.; Azinheiro, S.; Mota, S.; Prado, M.; Lamas, A.; Garrido-Maestu, A. Assessment of the Presence of Acinetobacter Spp. Resistant to β-Lactams in Commercial Ready-to-Eat Salad Samples. Food Microbiol. 2024, 118, 104410. [Google Scholar] [CrossRef]
- Kittinger, C.; Kirschner, A.; Lipp, M.; Baumert, R.; Mascher, F.; Farnleitner, A.H.; Zarfel, G.E. Antibiotic Resistance of Acinetobacter Spp. Isolates from the River Danube: Susceptibility Stays High. Int. J. Environ. Res. Public. Health 2018, 15, 52. [Google Scholar] [CrossRef]
- Gülbüz, M.; Saral Sariyer, A. Combined in Silico Approach and Whole Genome Sequencing: Acinetobacter Baumannii ST218 Isolate Harboring ADC-73 β-Lactamase Which Has a Similar C-Loop with ADC-56 and ADC-68 β-Lactamase. J. Mol. Graph. Model. 2022, 114, 108195. [Google Scholar] [CrossRef]
- Aminharati, F.; EhrampoushH, M.H.; Soltan Dallal, M.M.; Yaseri, M.; Dehghani Tafti, A.A.; Rajabi, Z. Citrobacter Freundii Foodborne Disease Outbreaks Related to Environmental Conditions in Yazd Province, Iran. Iran. J. Public Health 2019, 48, 1099–1105. [Google Scholar] [CrossRef]
- Hirai, Y.; Asahata-Tago, S.; Ainoda, Y.; Fujita, T.; Kikuchi, K. Edwardsiella Tarda Bacteremia. A Rare but Fatal Water- and Foodborne Infection: Review of the Literature and Clinical Cases from a Single Centre. Can. J. Infect. Dis. Med. Microbiol. 2015, 26, 702615. [Google Scholar] [CrossRef]
- Griffiths, J.K. Waterborne Diseases. In International Encyclopedia of Public Health; Elsevier: Amsterdam, The Netherlands, 2017; pp. 388–401. ISBN 978-0-12-803708-9. [Google Scholar]
- Ruppé, É.; Woerther, P.-L.; Barbier, F. Mechanisms of Antimicrobial Resistance in Gram-Negative Bacilli. Ann. Intensive Care 2015, 5, 21. [Google Scholar] [CrossRef] [PubMed]
- Duran-Bedolla, J.; Téllez-Sosa, J.; Bocanegra-Ibarias, P.; Schilmann, A.; Bravo-Romero, S.; Reyna-Flores, F.; Villa-Reyes, T.; Barrios-Camacho, H. Citrobacter spp. and Enterobacter spp. as Reservoirs of Carbapenemase blaNDM and blaKPC Resistance Genes in Hospital Wastewater. Appl. Environ. Microbiol. 2024, 90, e01165-24. [Google Scholar] [CrossRef] [PubMed]
- Caliskan-Aydogan, O.; Alocilja, E.C. A Review of Carbapenem Resistance in Enterobacterales and Its Detection Techniques. Microorganisms 2023, 11, 1491. [Google Scholar] [CrossRef]
- Loiodice, M.; Ribeiro, M.; Peixe, L.; Novais, Â. Emergence of NDM-1 and KPC-3 Carbapenemases in Kluyvera Cryocrescens: Investigating Genetic Heterogeneity and Acquisition Routes of blaNDM-1 in Enterobacterales Species in Portugal. J. Glob. Antimicrob. Resist. 2023, 34, 195–198. [Google Scholar] [CrossRef]
- Vatterrodt, D.; Lee, J.; Ho, D.; Stevig, C.; Chow, S.-K. Misidentification and Misreporting of Antibiotic Resistance in Kluyvera Bacteremia by Blood Culture Molecular Identification Panels. Microbiol. Spectr. 2024, 12, e00542-24. [Google Scholar] [CrossRef]
- Anokyewaa Appau, A.A.; Ofori, L.A. Antibiotic Resistance Profile of E. Coli Isolates from Lettuce, Poultry Manure, Irrigation Water, and Soil in Kumasi, Ghana. Int. J. Microbiol. 2024, 2024, 6681311. [Google Scholar] [CrossRef]
- Ratshilingano, M.T.; du Plessis, E.M.; Duvenage, S.; Korsten, L. Characterization of Multidrug-Resistant Escherichia Coli Isolated from Two Commercial Lettuce and Spinach Supply Chains. J. Food Prot. 2022, 85, 122–132. [Google Scholar] [CrossRef] [PubMed]
- Cantón, R.; Coque, T.M. The CTX-M β-Lactamase Pandemic. Curr. Opin. Microbiol. 2006, 9, 466–475. [Google Scholar] [CrossRef]
- Farzin, A.; Rahman, M.M.; Mollika, F.A.; Farzin, A.; Rahman, M.M.; Mollika, F.A. Pseudomonas aeruginosa: The Alarming Pathogen of Hospital Acquired Infection. In Pseudomonas aeruginosa—New Perspectives and Applications; IntechOpen: London, UK, 2023; ISBN 978-1-80356-825-6. [Google Scholar]
- Mekonnen, H.; Seid, A.; Fenta, G.M.; Gebrecherkos, T. Antimicrobial Resistance Profiles and Associated Factors of Acinetobacter and Pseudomonas Aeruginosa Nosocomial Infection among Patients Admitted at Dessie Comprehensive Specialized Hospital, North-East Ethiopia. A Cross-Sectional Study. PLoS ONE 2021, 16, e0257272. [Google Scholar] [CrossRef]
- Catho, G.; Martischang, R.; Boroli, F.; Chraïti, M.N.; Martin, Y.; Koyluk Tomsuk, Z.; Renzi, G.; Schrenzel, J.; Pugin, J.; Nordmann, P.; et al. Outbreak of Pseudomonas Aeruginosa Producing VIM Carbapenemase in an Intensive Care Unit and Its Termination by Implementation of Waterless Patient Care. Crit. Care 2021, 25, 301. [Google Scholar] [CrossRef]
- Wei, L.; Wu, Q.; Zhang, J.; Guo, W.; Gu, Q.; Wu, H.; Wang, J.; Lei, T.; Xue, L.; Zhang, Y.; et al. Prevalence, Virulence, Antimicrobial Resistance, and Molecular Characterization of Pseudomonas Aeruginosa Isolates From Drinking Water in China. Front. Microbiol. 2020, 11, 544653. [Google Scholar] [CrossRef] [PubMed]
- Georgakopoulou, V.E.; Avramopoulos, P.; Papalexis, P.; Bitsani, A.; Damaskos, C.; Garmpi, A.; Gkoufa, A.; Garmpis, N.; Mantzouranis, K.; Chlapoutakis, S.; et al. Exacerbation of Bronchiectasis by <em>Pseudomonas Putida</Em> Complicating COVID-19 Disease: A Case Report. Exp. Ther. Med. 2021, 22, 1452. [Google Scholar] [CrossRef]
- Lee, D.; Jung, K.H.; Son, H.-J.; Moon, I.T. Pseudomonas Monteilii Bacteremia and Sepsis Following Insertable Cardiac Monitor Implantation: A Case Report. J. Med. Case Rep. 2024, 18, 480. [Google Scholar] [CrossRef] [PubMed]
- Silva, A.; Silva, V.; Igrejas, G.; Poeta, P. Carbapenems and Pseudomonas aeruginosa: Mechanisms and Epidemiology. In Antibiotics and Antimicrobial Resistance Genes in the Environment; Hashmi, M.Z., Ed.; Advances in Environmental Pollution Research series; Elsevier: Amsterdam, The Netherlands, 2020; Volume 1, pp. 253–268. ISBN 978-0-12-818882-8. [Google Scholar]
- Ntshanka, Z.; Ekundayo, T.C.; du Plessis, E.M.; Korsten, L.; Okoh, A.I. Occurrence and Molecular Characterization of Multidrug-Resistant Vegetable-Borne Listeria Monocytogenes Isolates. Antibiotics 2022, 11, 1353. [Google Scholar] [CrossRef] [PubMed]
- Adefisoye, M.A.; Okoh, A.I. Identification and Antimicrobial Resistance Prevalence of Pathogenic Escherichia Coli Strains from Treated Wastewater Effluents in Eastern Cape, South Africa. Microbiologyopen 2016, 5, 143–151. [Google Scholar] [CrossRef]
- Agyare, C.; Boamah, E.V.; Zumbi, N.C.; Osei, B.F. Antibiotic Use in Poultry Production and Its Effects on Bacterial Resistance. In Antimicrobial Resistance—A Global Threat; IntechOpen: London, UK, 2019; ISBN 978-1-78985-783-2. [Google Scholar]
- Mikhayel, M.; Doublet, B.; Sarkis, D.K. Antimicrobial Resistance of Enterobacteriaceae in Poultry in Lebanon. In Proceedings of the 15. Congrès National de la Société Française de Microbiologie (SFM), Paris, France, 30 September 2019; p. 436. [Google Scholar]
Disclaimer/Publisher’s Note: The statements, opinions and data contained in all publications are solely those of the individual author(s) and contributor(s) and not of MDPI and/or the editor(s). MDPI and/or the editor(s) disclaim responsibility for any injury to people or property resulting from any ideas, methods, instructions or products referred to in the content. |
© 2025 by the authors. Licensee MDPI, Basel, Switzerland. This article is an open access article distributed under the terms and conditions of the Creative Commons Attribution (CC BY) license (https://creativecommons.org/licenses/by/4.0/).